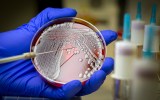

An experimental antibiotic that targets antibiotic-resistant ‘superbugs’ has proved to be safe and well tolerated in a Phase 1 clinical trial.
The new drug, QPX9003, was developed by Monash University researchers – and offers some real hope to holding off a predicted ‘superbug’ catastrophe.
The World Health Organisation has warned that gram-negative bacterial ‘superbugs’ – such as pneumonia, bloodstream infections, urinary tract infections, peritonitis and meningitis – could kill 10 million people a year by 2050.
Overall, this would make ‘superbugs’ the No.1 lethal disease in the world.
What kind of drug is it?
The new drug is a synthetic lipopeptide.
A lipopeptide antibiotic works by disrupting the membrane of a target bacteria and this sets off a chain of events that leads to cell death.
In pub terms, the drug causes the bug to empty its guts out.
This is the first lipopeptide antibiotic to be developed in more than 60 years – and in fact, doctors still reply on two ancient lipopeptides as the last line of defence against gram-negative bacteria.
These old drugs, Polymyxin B and Colistin, have two problems:
- They’re nephrotoxic (causing rapid decline in kidney function) and for a time they were abandoned, except for use in people with cystic fibrosis. But with the rise of the ‘superbug’ – and literature suggesting that maybe they’re not quite as toxic as once thought – they’ve had as comeback
- The superbugs are becoming resistant to them.
Hence, the excitement that the new synthesised lipopeptide was shown to be both safe and tolerable.

“These Phase I results are very inspiring as the currently used treatments, Polymyxin B and Colistin, display significant toxicity issues in the clinic that have severely limited their use”, said Professor Jian Li who heads up the Monash antibiotic drug discovery program.
“These results showing the safety and tolerability for QPX9003 at clinically relevant doses is critical and demonstrates that QPX9003 has the potential to be administered at significantly higher doses than Polymyxin B and Colistin without adverse effects.”
What happened in the clinical trial?
The Phase I study was conducted by the US-based biopharmaceutical company Qpex Biopharma – which worked with Monash to support the development of QPX9003, and eventually licensed the drug in 2019.
The clinical trial involved 101 participants and was conducted over a 13-month period. None of the participants dropped out, which is highly significant.
According to a statement from Monash, data shows that the drug was well tolerated in single-dose escalation up to 400mg and multiple doses up to 600mg per day for 14 days.
No nephrotoxicity or other significant adverse events were observed and, importantly, no subjects discontinued the trial.
It is anticipated that QPX9003 can be safely dosed at levels that would be sufficient to achieve clinical efficacy and warrants further clinical development.
“These results showing the safety and tolerability for QPX9003 at clinically relevant doses is critical and demonstrates that QPX9003 has the potential to be administered at significantly higher doses than Polymyxin B and Colistin without adverse effects.”
Will it come as a pill from the chemist?
Dr Kade Roberts is research fellow at Monash’s Biomedicine Discovery Institute, and the chemistry team leader of the group that developed the antibiotic.
He told The New Daily that QPX9003 is an intravenously administered drug that would be confined to use in hospitals, once it has been approved for clinical use.
Now the Phase I clinical trial has been completed, “Qpex Biopharma will next meet with regulators to discuss the next steps toward studies in patients”.
Where the Phase I trial involved healthy volunteers, the next step is a Phase II trial with patients battling gram-negative bacterial diseases. Some of these will be given the new drug, others a placebo.
All going well, a large Phase III trial would investigate efficacy and safety in a larger population.
Dr Roberts didn’t know when these next trials would occur, or where.
The results of the trial have not yet been peer reviewed, but data from the trial was presented at IDWeek 2022 in Washington DC in October.
If you’re keen to know more about the drug’s development, see here.